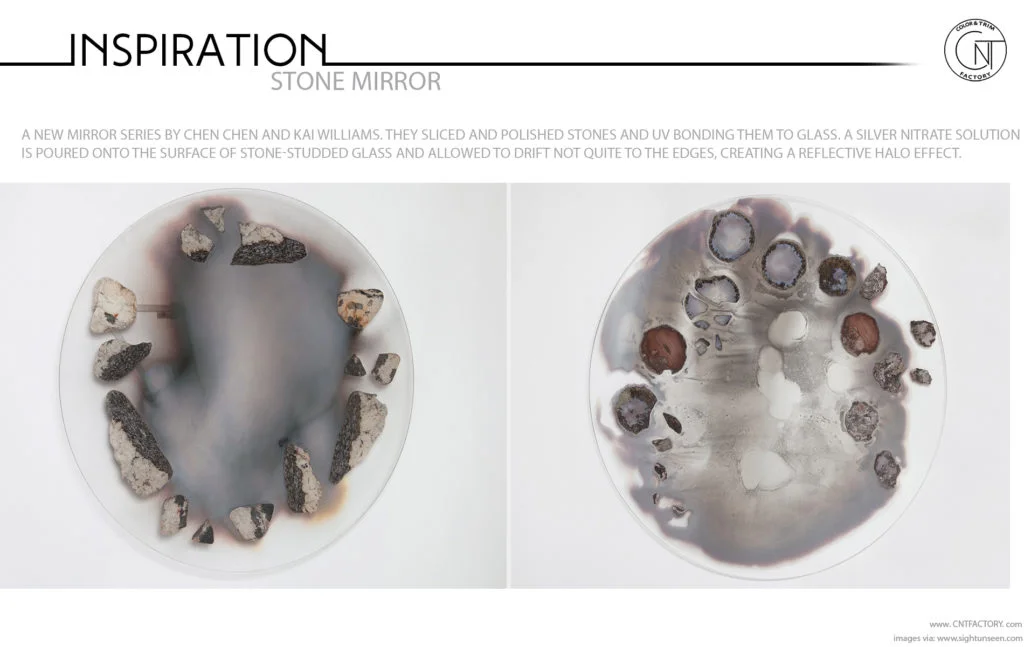
stone mirror

Related Post: Tactile Volcanic Rock / Maison & Objet / Concrete
The new mirror series consists of a silver nitrate solution is poured onto the surface of stone-studded glass and allowed to drift not quite to the edges, creating a reflective halo effect. In a hydra-headed plant stand, a metal structure equally resembles the veins of a plant and the vascular system of the human body. And in the so-called “stone roses” that make up the structure of their lighting system, each “petal” is cut using a saw, not unlike a diamond cutter, that’s been submerged in mineral oil — the trick is to cut them translucent enough to transmit light but not so thin that they shatter.